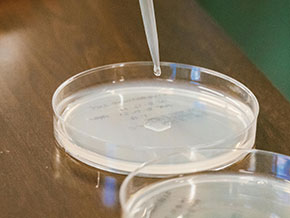

About

CHALLENGE & VISION
Plastics pervade many industries, with production soaring from 1.5 Mt in 1950 to 359 Mt in 2019, and virgin plastics reaching 8,000 Mt in 2020. The result? A surge in plastic waste and environmental threats, with 20 Mt entering aquatic ecosystems annually—dubbed the "7th continent of plastic." Traditional waste management is failing, driving the need for sustainable solutions.
TwInn4MicroUp leads with an innovative approach, transforming plastic monomers, derived from green plastic depolymerization technologies, into high-value biomaterials and bioactive compounds via Synthetic Microbial Biotechnology.
This project aims to build an EU value chain, converting single-use and hard-to-recycle plastics into next-generation bioactive compounds and biomaterials, ensuring high environmental and economic value.
OBJECTIVES
Establishment of a high-performance Research and Innovation Hub for Synthetic Microbial Biotechnology, elevating NTUA’s profile, addressing the innovation gap between the European countries while delivering impactful socio-enviro-economic outputs via new circular petro- and bio- plastics lifecycles.

STRUCTURE
Work Package 1
Project Management and Coordination
WP1 ensures effective project operation by meeting goals within defined timelines and budgets. Results will be shared via Intellectual Property Rights and Exploitation Board (IPREB) and Dissemination and Exploitation Board (DEB), with clear communication channels established through periodic meetings, emails, teleconferences, and a file repository platform. Additionally, a mobile app will be developed for real-time project monitoring, fostering remote collaboration and improving efficiency. This initiative aims to enhance productivity and alignment with project objectives.
NTUA
Work Package 2
Cross-pollination Activities: Networking and Training
To enhance NTUA's research and innovation, the proposal includes seven short-term staff exchanges and three workshops and training schools. Workshops will showcase state-of-the-art achievements, mainly for NTUA researchers, while training schools will offer broader, presentation-style lectures on Modern Synthetic Biology. Three annual training schools will continue post-project to sustain the TwInn4MicroUp Hub, offering travel grants for early-stage researchers. The initiative aims to foster sustainable partnerships and collaborative efforts, contributing to NTUA's long-term scientific agenda and promoting resource sharing and best practices.
UNIBA
Work Package 3
Synthetic Microbial Biotechnology for Plastic Waste Upcycling
WP3 focuses on developing yeast and bacterial strains to produce bio-products from depolymerized plastic waste. Leveraging advanced synthetic biology and strain engineering, TUS will utilize green methodologies for plastic degradation. NTUA, a leader in enzymatic plastic degradation, will provide pretreated materials for microbial valorization. IMGGE will enhance bacterial strains using CRISPR/Cas9 and Adaptive Laboratory Evolution, while UNIBA will engineer yeast strains to increase lipid accumulation. Improved strains will be cultivated in bioreactors for large-scale production of bio-products.
NTUA
Work Package 4
Enhancement of research management and administrative skills of NTUA
WP4 focuses on enhancing NTUA’s research management by assessing current capabilities, identifying areas for improvement, and aligning with the institution's mission. Expertise from TUS and IMGGE will help establish a dedicated research office. Administrative processes will be streamlined, including grant applications and project reporting. Workshops, seminars, and staff exchanges will be organized to enhance skills. A dedicated RMA Office for EU projects will be established at NTUA, collaborating with TUS to improve project management and administration.
TUS
Work Package 5
Synergistic Industrial Engagement for Incubation of Innovation
WP5 will establish the TwInn4MicroUp Hub by leveraging networking activities among Consortium members and the LIEE network. This initiative will focus on developing microbial strains for valorizing industrial side streams. To attract diverse stakeholders, events like the Academy-Industry Forum and Circular Economy and Bioeconomy Festival will be organized, covering the latest achievements and fostering networking opportunities. Connections with organizations like Hellenic Federation of Enterprises (SEV) and Research and Entrepreneurship Unit (REU) at NTUA will be established. An online innovation competition, the "MicroUp Challenge", will incubate innovative ideas in Synthetic Microbial Biotechnology.
NTUA
Work Package 6
Outreach, Communication and Dissemination
WP6 focuses on dissemination, exploitation, and communication (DEC) to ensure long-term sustainability. A comprehensive DEC plan will promote project activities and engage various stakeholders, including the public, students, industry professionals, and policymakers. Project outcomes will be disseminated through scientific publications. To sustain the TwInn4MicroUp Hub, applications for Joint Research Projects under HE programs, and Greek national funds will be pursued.
IMGGE



IMPACT
TwInn4MicroUp is set to redefine our approach to plastic waste management by harnessing the power of Synthetic Microbial Biotechnology, turning plastic waste into valuable resources, aligning with the principles of a circular and sustainable economy. The innovative solutions within this project hold the potential to mitigate the environmental impact of plastic waste while creating economic value and fostering new avenues of research and development.
